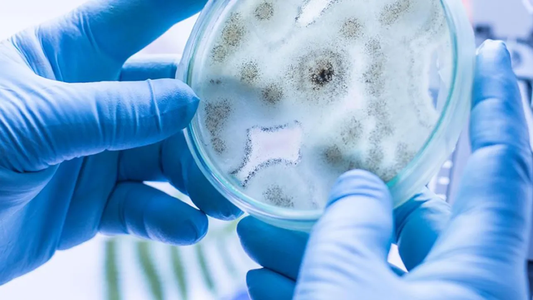
Candida auris | Se detectaron dos casos en Argentina: qué es y cómo actúa el súper hongo

El Ministerio de Salud de Nación informó este miércoles que "continúa en proceso" la investigación epidemiológica tras la detección de los dos primeros casos de Candida auris, una especie de hongo que crece como la levadura, provenientes de muestras de pacientes tratados en una clínica de la Ciudad Autónoma de Buenos Aires (CABA), que "no compartieron el mismo ámbito en el mismo momento".
Candida auris | Se detectaron dos casos en Argentina: qué es y cómo actúa el "súper hongo"
Candida auris: el Ministerio de Salud de Nación informó este miércoles que "continúa en proceso" la investigación epidemiológica tras la detección de los dos primeros casos (Foto: NA)
Las muestras clínicas fueron identificadas el viernes pasado en un laboratorio privado de CABA a través de la técnica de MALDI-TOF y derivadas al Laboratorio Nacional de Referencia en Micología Clínica (LNRM) del Instituto Nacional de Enfermedades Infecciosas (INEI) de la Administración Nacional de Laboratorios e Institutos de Salud (Anlis) “Dr. Carlos G. Malbrán”.
Ante esta situación, se procedió a informar a la Gerencia Operativa de Epidemiología del Ministerio de Salud de la Ciudad Autónoma de Buenos Aires y se realizó una reunión conjunta entre las autoridades y personal de la institución privada, equipos técnicos de la ciudad y del Ministerio de Salud de la Nación, se informó a través de un comunicado de prensa.
Paralelamente, el LNRM confirmó en un segundo diagnóstico la identificación de Cándida auris en las muestras enviadas, realizó los estudios de sensibilidad a los antifúngicos y asesoró al personal a cargo para poder ofrecer el tratamiento adecuado, detalló la cartera de salud.
Candida auris: cómo se detectaron los dos casos en Ciudad
Uno de los aislamientos proviene de un paciente internado desde el 2 de octubre en la unidad de cuidados intensivos de una clínica de CABA, quien fue derivado de una clínica del exterior del país, trasladado en un vuelo sanitario y, actualmente, permanece internado.
El 18 de octubre se le realizó un urocultivo con aislamiento de Cándida, que el 28 de octubre fue identificado como Cándida auris en un laboratorio privado.
Las autoridades sanitarias argentinas enviaron "un requerimiento de información al país de procedencia del caso sobre antecedentes de patógenos en la clínica donde estuvo internado uno de los pacientes".
El otro aislamiento corresponde a un paciente que fue tratado de forma ambulatoria en la misma clínica, donde el 13 de octubre se le realizó un cultivo de líquido peritoneal donde se aisló una levadura posteriormente identificada como Cándida auris.
Los pacientes "no compartieron el mismo ámbito en el mismo momento" durante su estadía en la clínica y la investigación epidemiológica "continúa en proceso", informaron.
Qué es el Candida auris y cómo actúa
El Candida auris fue descubierto en 2009. Es resistente a muchos medicamentos y mortal en alrededor del 39% de los casos, por lo que llegó a conocerse como un superhongo y podría causar una candidiasis que puede presentarse de manera superficial, por ejemplo, en la piel, o ser profunda.
Además se indicó que el hongo es más letal en pacientes que tienen otros problemas de salud, lo que facilita el desarrollo de la forma sanguínea que puede llevar a la muerte y se transmite a través del contacto con ambientes contaminados o con personas colonizadas, mientras que puede persistir en el ambiente hospitalario por semanas.
El Cándida auris fue reportado como agente causal de infecciones invasoras en humanos en al menos 47 países.